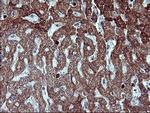
MMP13 Antibody in Immunohistochemistry (Paraffin) (IHC (P))

Search
OriGene
MMP13 Monoclonal Antibody (OTI2D8), TrueMAB™
{{$productOrderCtrl.translations['antibody.pdp.commerceCard.promotion.promotions']}}
{{$productOrderCtrl.translations['antibody.pdp.commerceCard.promotion.viewpromo']}}
{{$productOrderCtrl.translations['antibody.pdp.commerceCard.promotion.promocode']}}: {{promo.promoCode}} {{promo.promoTitle}} {{promo.promoDescription}}. {{$productOrderCtrl.translations['antibody.pdp.commerceCard.promotion.learnmore']}}
产品信息
TA506806
种属反应
宿主/亚型
分类
类型
克隆号
抗原
偶联物
形式
浓度
规格
纯化类型
保存液
内含物
保存条件
运输条件
靶标信息
MMP13 (collagense 3) plays a role in the degradation of extracellular matrix proteins including fibrillar collagen, fibronectin, TNC, and ACAN. MMP13 cleaves tripal helical collagens, including type I, II, and III collagen - but has the highest activity with soluble type II collagen. It can degrade collagen type IV, XIV, and X. MMP13 plays a role in wound healing, tissue remodeling, cartilage degradation, bone development, bone mineralization, and ossification. It is required for normal embryonic bone development and ossificaiton. Mutations affecting the gene can lead to spondyloepimetaphyseal dysplasia Missouri type, metaphyseal anadysplasia 1, and metaphyseal dysplasia Sphar type.
仅用于科研。不用于诊断过程。未经明确授权不得转售。
篇参考文献 (0)
生物信息学
蛋白别名: Collagenase; Collagenase 3; Collagenase3; matrix metallo protease; matrix metalloproteinase 13 (collagenase 3); Matrix metalloproteinase-13; MMP; MMP-13; MMPs; Procollagenase 3; unnamed protein product
基因别名: CLG3; MANDP1; MDST; MMP-13; MMP13
UniProt ID: (Human) P45452
Entrez Gene ID: (Human) 4322